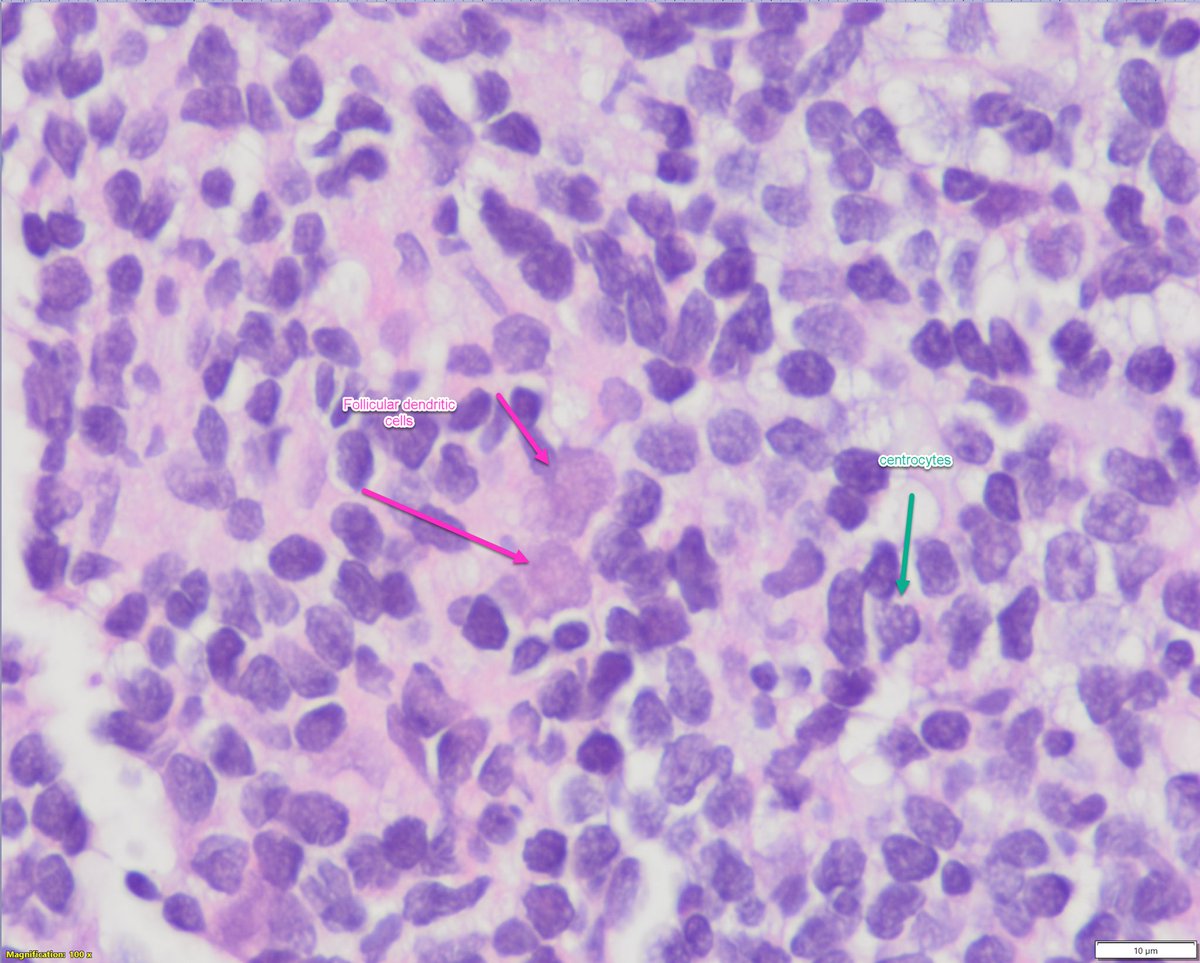
Sanam Loghavi, MD صنم لغوی 🔬🧬 tweet media

Dr . Reenal Patel
193 posts


Dr . Reenal Patel
@reenal_
PGY3 Pathology Resident at Corewell Health East, Michigan. Interested in Hemepath/Molecular Path/Cytopath | Spiritual Seeker. Nature lover.
Michigan, USA Katılım Eylül 2013
1.4K Takip Edilen870 Takipçiler

Thrilled to receive 3rd place in the CAP 2025 Junior Member Abstract Award 🏆 (out of 300+ submissions)!
Grateful to Dr. Jabbar for guidance, my colleagues @Srksamejo2 @GonzaloCantuS for equal contributions, and my family for their unwavering support.
@pathologists #CAP25

English

@fouad_boulos I would call it microglandular adenosis if p63 is negative.
English

Hi everyone! Sorry to have been posting so infrequently for the past few months.
I will go back to regular posts and can't wait to interact with everyone about interesting #breastpath cases.
I will try the format I originally intended, one consult case per week, posted on Monday/Tuesday and discussed on Friday. Let's see how that goes.
Breast Consult Case of the Week 1 #BCCW:
50 year old with non-mass enhancement on MRI.
What is the consulting pathologist's question(s) and what is your interpretation? (third image depicts p63 IHC)
See you Friday! #PathTwitter #PathX @washupathedu @washu_pathology



English

@MeredithKHerman @Pathologists @DrBuiPathology Hi Meredith.. I am all in for this. Let me know what needs to be done.
English

Calling #pathology residents attending @Pathologists #CAP2025! We're looking for volunteers to help at our booth: "Residency in Pathology’s Digital Era: Ask Me Anything" at the CAP #DigPath Innovation Hub on Sunday, 9/14, 11:15–11:45 AM.
Please DM if interested!
@DrBuiPathology
GIF
English
Dr . Reenal Patel retweetledi

🔥A TIP for diagnosing MALT Lymphoma starts with low magnification.
🎯I search for the muscularis mucosa and see it at the highest magnification.
👉Physiologic lymphoid collection typically does not infiltrate the muscularis mucosa.
Here is a gastric MALT Lymphoma.
#gipath


English

I’m humbled and beyond thrilled to share that I’ve matched into #HemePath fellowship at @BIDMCpath ! 😊
I feel fortunate to have interviewed with some of the most outstanding people in our field 🤗
Deepest thanks to my friends & mentors!
#HemePathMatch26 @SocforHemepath ✨

English

TERRIFYING case! 80 M pink papule nose.
Answer ✅ youtu.be/Ok5axr0NDgY?si…
Digital slides & IHC: kikoxp.com/posts/21794
Clinical photo (I would've NEVER guessed dx from this!): kikoxp.com/posts/21799
#pathology #pathologists #pathTwitter #dermpath #dermatology #dermtwitter

YouTube




English
Dr . Reenal Patel retweetledi

Low power frozen section Friday.
Organ?
Diagnosis?
You really have to take a thorough 👀 to spot this one!
Close-ups & bonus case to come!
#PathTwitter

English
Dr . Reenal Patel retweetledi

Organ? Diagnosis?
Hint: the lesion is benign, its abbreviation is the same as a malignant entity, & IHC used for diagnosis is the same used to diagnose another malignant tumor. #PathTwitter #PathX #Pathology


English

@MaiElzieny @cpschukow @Anders0nj @AshbitaP @Srksamejo2 Where is the gold necklace that the duck had ?🫣 One side pose too for the duck ❤️
English

I was voted by my co-residents to won this cute award today! Although it was for an award for the resident with the worst call week, but an award is an award regardless 😂😂😂 thanks for appreciating my⛈️ guys!
@cpschukow @Anders0nj @AshbitaP @reenal_ @Srksamejo2

English

My GU rotation reminds me of how fun pathology is!for example: 3+4 is not the same as 4+3, Verumontanum is not a spa or a resort, and ASAP has a completely different & “atypical”meaning! #pathology #PathTwitter #PathX
English
Dr . Reenal Patel retweetledi
Dr . Reenal Patel retweetledi

An aspergilloma is a collection of Aspergillus fungal hyphae sitting within a dilated bronchial lumen. Does not invade tissue but can erode bronchus and cause hemoptysis. Also called fungus ball or mycetoma.
#Pathbugs #crittersontwitter #pathology #pulmpath



English
Dr . Reenal Patel retweetledi

On behalf of our residency program, we would like to send a special shout-out and #blessed wishes to all the mothers out there this weekend. Happy Mother’s Day! #MothersDay2024 #PathX #PathMoms
GIF
English
Dr . Reenal Patel retweetledi